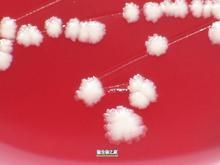
傑氏棒桿菌 傑氏棒桿菌

信息
傑氏棒桿菌ATCC43734
【產品ID號】47119
【產品編號】CL1901
【中文名稱】傑氏棒桿菌ATCC43734
【英文名稱】 英文名:CorynebacteriumjeikeiumATCC43734
【產品規格】5支/包裝
【產品類別】質控菌株>>Remel質控菌株
Culti-Loops質控菌株接種環為5支/包裝,除彎曲菌屬需冷凍保存(-18℃)外,其它都應在2-8℃保存。
傑氏棒桿菌ATCC43734
D-氨基葡萄糖鹽酸鹽/葡糖胺鹽酸鹽/葡萄糖胺鹽酸鹽/2-氨基-2-脫氧-D-氨基葡萄糖鹽酸鹽/鹽酸氨基葡萄糖/鹽酸甲殼質/D-GlucosamineHC1
D-半胱氨酸/(S)-2-氨基-3-巰基丙酸/D-Cysteine
D-半胱氨酸鹽酸一水化合物/D-β-巰基丙氨酸鹽酸鹽/D-Cysteinehydrochloridemonohydrate
簡介
以海藻酸鈉為載體將篩選出的傑氏棒桿菌進行固定化包埋,並對固定化菌降解LAS廢水進行了實驗研究。結果表明:在不同的溫度和pH值條件下,固定化菌的適應範圍比游離菌有所擴大,適宜的溫度為20~35℃,pH為5~9;固定化菌降解不同濃度的LAS廢水過程遵循一級反應。隨濃度的提高,降解速率常數增大,當濃度超過300mg/L後,降解速率常數又開始減小。該菌的形態、生理生化等特徵,採用美國BiologMicrostationIdentificationSystem自動化鑑定系統,初步鑑定其為傑氏棒桿菌CorynebacteriumJeikeiumGZ6.